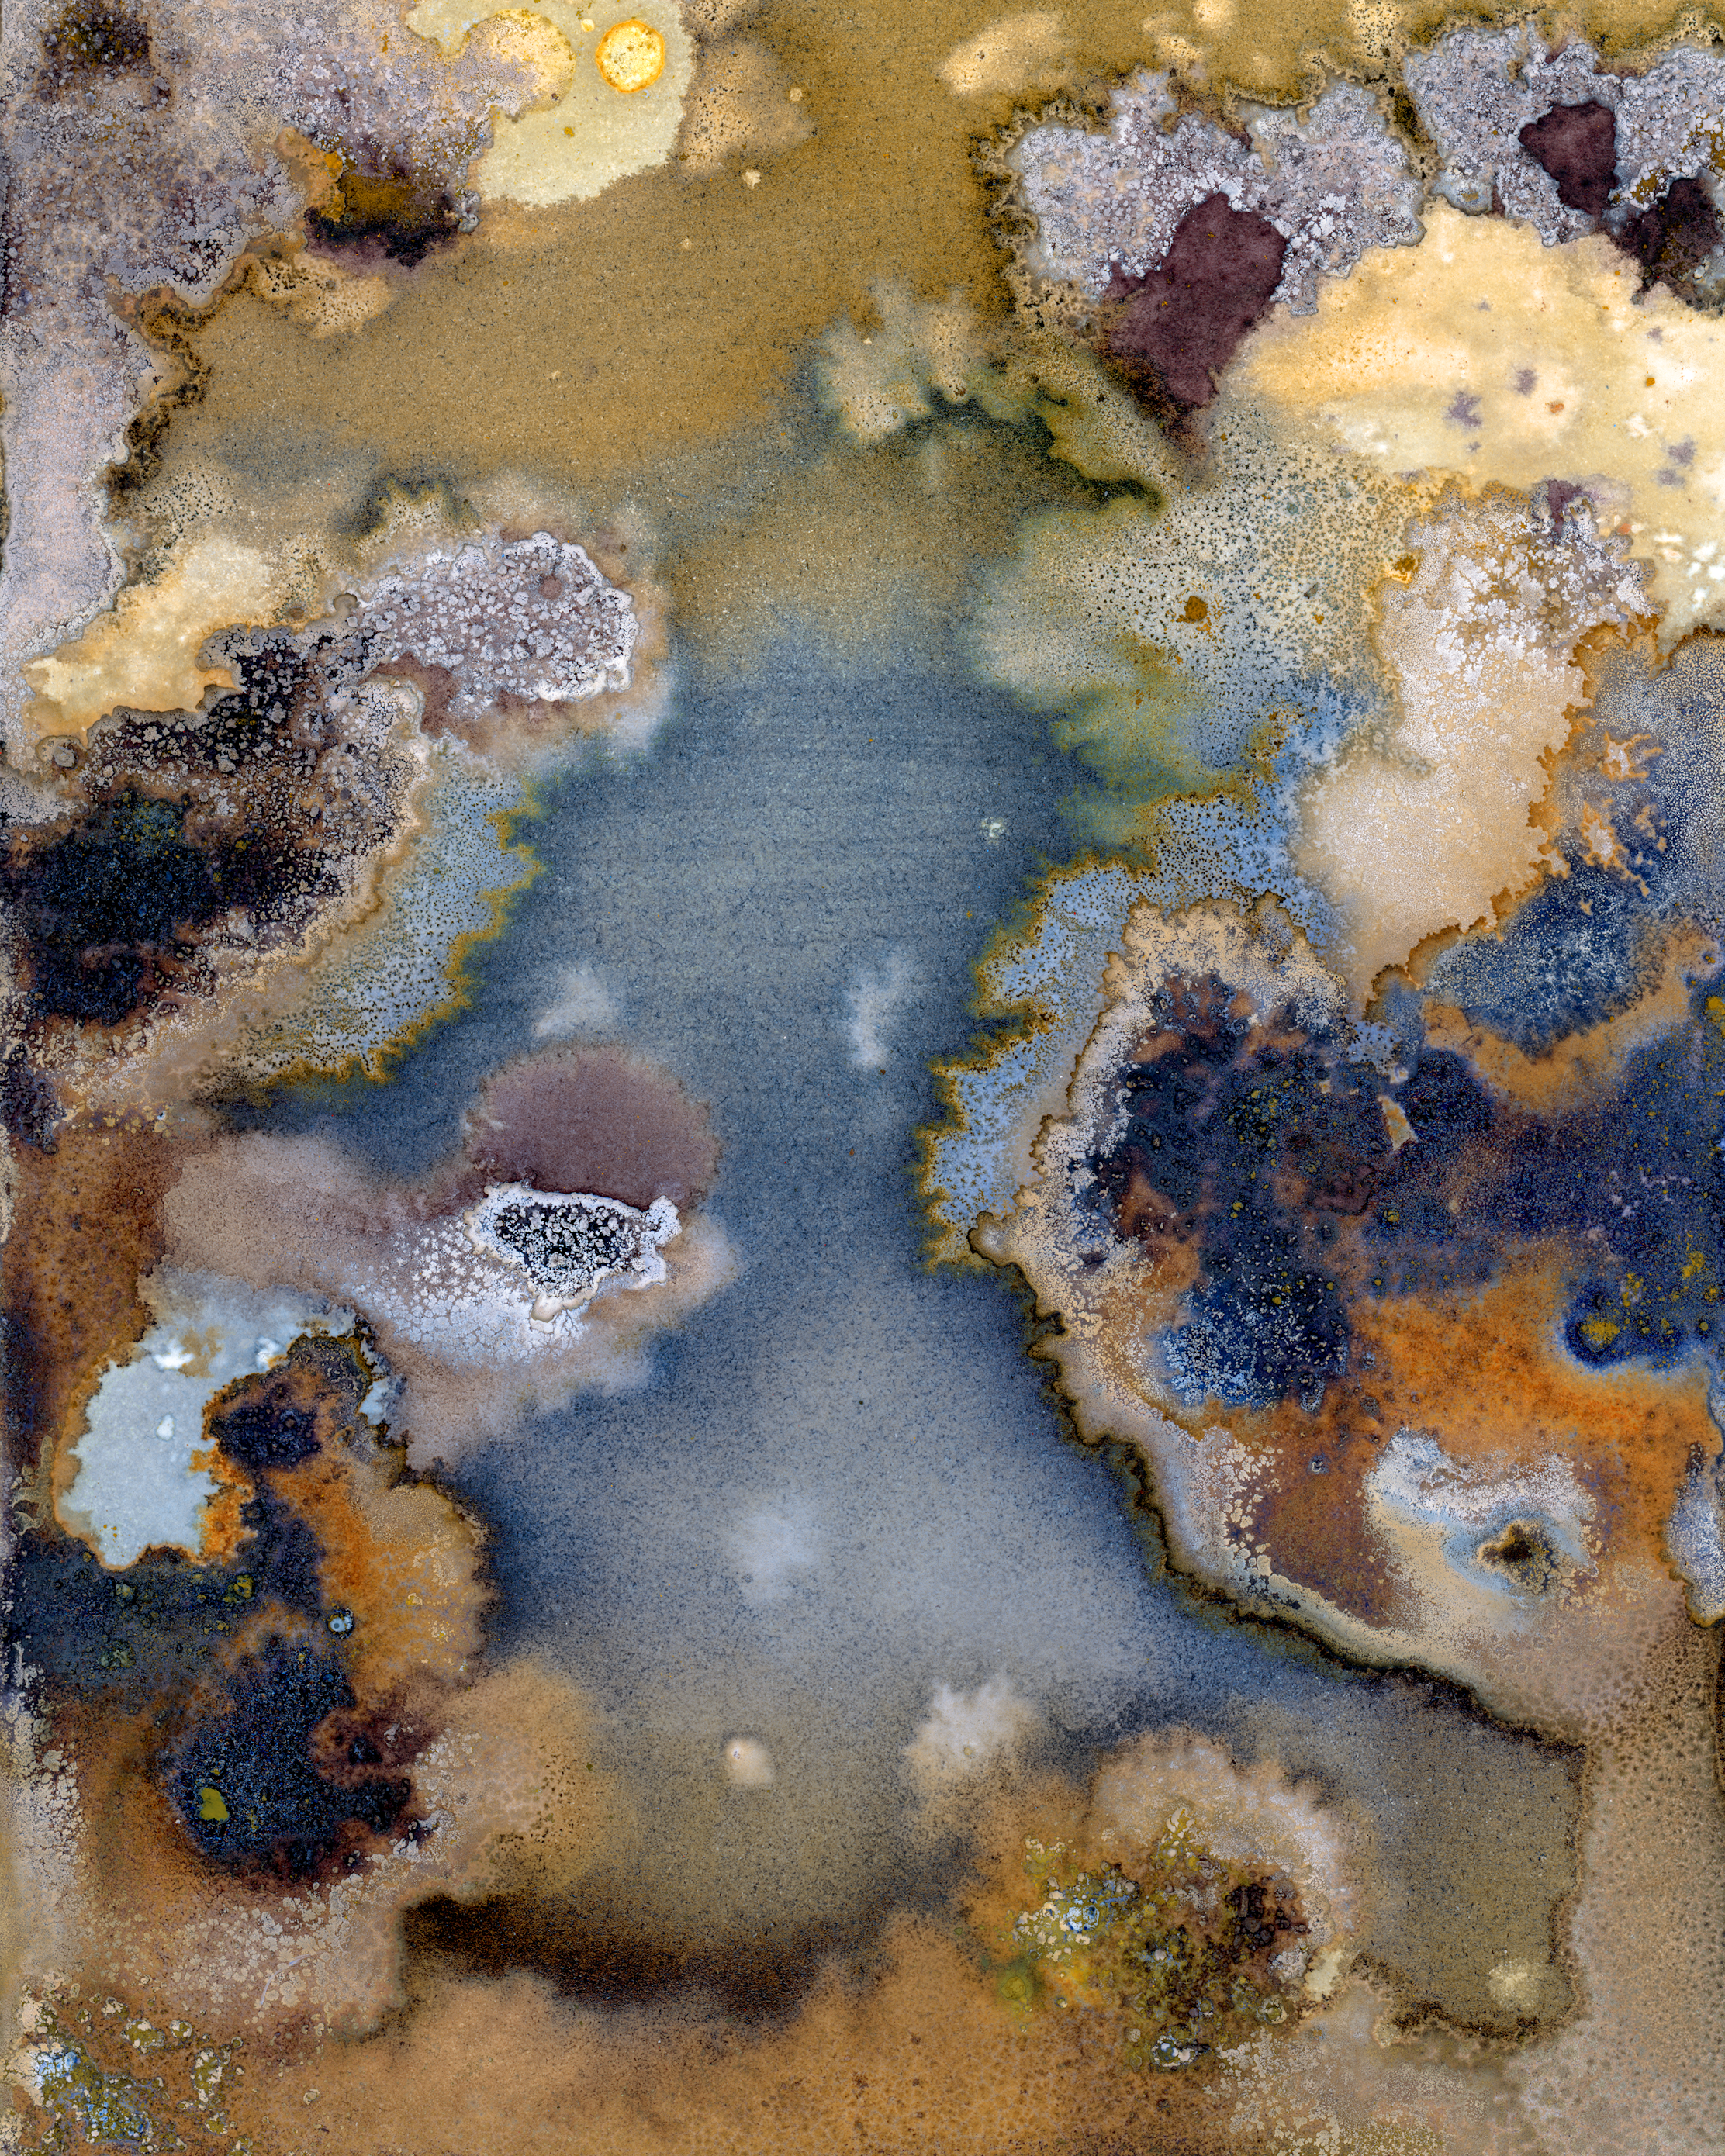

Full Size
pH2
0xC4e...6C545
Chemical reactions between light-sensitive medium, minerals, natural pigments, rust and acids on paper. Scanned & digitally enhanced.
Fine art paper prints can be claimed for fixed price pieces and all auctions that settle for the same amount of more.
- MediumImage (PNG)
- File Size25.9 MB
- Dimensions3150 x 3938
- Contract Address
- Token StandardERC-721
- BlockchainEthereum